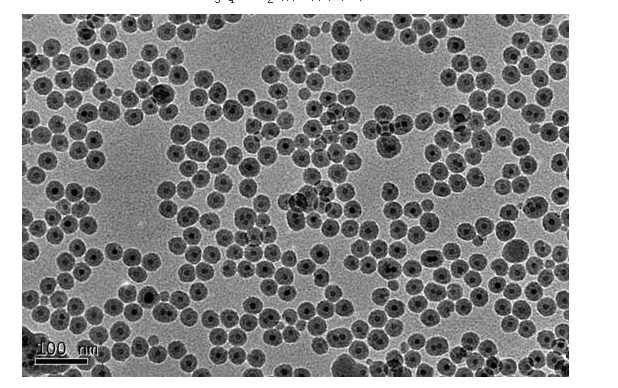
image.png

四氧化三铁磁性纳米颗粒(Fe3O4)的功能化修饰-特殊定制合成服务
油酸快件Fe3O4磁铁纳米级颗粒肥料疏散在环己烷中:
Fe3O4 Magnetic nanoparticles with oleic acid coating in Toluene /Cyclohexane
孔径:5nm-40nm 氧化还原电位:5mg/ml 包装机:5ml/10ml/更广
货号 | 粒级 | 酸度 |
QY-CY0505 | 5nm | 5mg/ml |
QY-CY1005 | 10nm | 5mg/ml |
QY-CY2005 | 20nm | 5mg/ml |
QY-CY3005 | 30nm | 5mg/ml |
(Fe304@SiO2剩磁納米粒子束TEM)
陕西pg电子娱乐游戏app 生物制品科技产业有限责任品牌对应企业产品说明:
DMSA@Fe3O4纳米技术a粒子(羧基掩盖)消减在水/有机质高沸点溶剂中
Fe3O4 Magnetic nanoparticles with DMSA carboxyl function in water/ Organic
颗粒直径:10nm-100nm 渗透压:2mg/ml
聚乙二醇邮包的Fe3O4剩磁nm颗粒状乳状液在水/充分萃取剂中
Fe3O4 Magnetic nanoparticles with PEG coating in water/ Organic
粒级:5nm-100nm 密度:5mg/ml
甲氧基功效化聚乙二醇包含的Fe3O4剩磁nm小粒发散在水/生产溶液中
Fe3O4 Magnetic nanoparticles with PEG coating methoxy function in water/ Organic
比表面积:5nm-30nm 盐浓度:1mg/ml
氨基功效化聚乙二醇快件的Fe3O4磁块纳米级粉末减少在水/有机物石油醚中
Fe3O4 Magnetic nanoparticles with PEG coating amine function in water/ Organic
粒度:5nm-30nm 含量:1mg/ml 内包装:2ml/5ml/更强
羧基功能表化聚乙二醇覆盖的Fe3O4带磁纳米级颗料分布在水/巧妙dmf溶剂中
Fe3O4 Magnetic nanoparticles with PEG coating carboxyl function in water/ Organic
孔径:5nm-20nm 渗透压:1mg/ml
聚合反应物-多聚赖氨酸(Poly-L-lysine/PLL)包装Fe3O4永磁铁纳米技术颗料解聚在水/有机酸容剂中
Fe3O4 Magnetic nanoparticles with Poly-L-lysine/PLL Polymer coating in water/ Organic
粒度分布:5nm-100nm 氧化还原电位:5mg /ml
缩聚物-聚氯乙烯亚胺(PEI)包着Fe3O4永磁铁nm颗粒剂扩散在水/生物碳石油醚中
Fe3O4 Magnetic nanoparticles with PEI Polymer coating in water/ Organic
粒度分布:5nm-100nm 酸度:5mg /ml
缩聚物-聚丁二烯亚胺(PEI)包着Fe3O4永磁铁納米粒状-氨基接触面作用化疏散在水/有机的溶液中
Fe3O4 Magnetic nanoparticles with PEI Polymer coating amine function in water/ Organic
孔径:5nm-20nm 含量:1mg /ml
可生物降解的功能键得碳原子(PLGA,PCL,PLA)包着Fe3O4磁铁微米科粒散落在水/无机高沸点溶剂中
Fe3O4 Magnetic nanoparticles with PLGA/PCL/PLA Polymer coating in water/ Organic
比表面积:5nm-100nm 溶度:5mg /ml
牛血清廉蛋白酶(BSA)邮包Fe3O4永久磁铁纳米级科粒乳状液在水/有机会萃取剂中
Fe3O4 Magnetic nanoparticles with BSA coating in water/ Organic
比表面积:5nm-40nm 渗透压:5mg /ml
链霉亲和素(Streptavidin)包Fe3O4磁铁奈米颗粒肥料分离在水/巧妙石油醚中
Fe3O4 Magnetic nanoparticles with Streptavidin coating in water/ Organic
孔径:5nm-40nm 渗透压:5mg /ml
油酸包含Fe3O4磁体纳米级粒子分散型在甲苯/环己烷中:
Fe3O4 Magnetic nanoparticles with oleic acid coating in Toluene /Cyclohexane
孔径:5nm-40nm 溶液浓度:5mg/ml
核壳型Fe3O4@SiO2納米a粒子疏散在水/设计液体中:
Fe3O4 Magnetic nanoparticles with SiO2 coating in water/ Organic
粒级:10nm-100nm 氨水浓度:2mg/ml
Fe3O4吸引力微米颗粒状扩散在水/有机的溶剂中
Fe3O4 Magnetic nanoparticles in water/ Organic
比表面积:5nm-100nm 盐浓度:5mg/ml
核壳型Fe3O4@SiO2納米塑料再生颗粒(氨基装饰)消减在水/有机物液体中
Fe3O4 Magnetic nanoparticles with SiO2 coating amine function in water/ Organic
粒度分布:10nm-100nm 浓硫酸浓度:2mg/ml


pg电子娱乐游戏app
微信公众号
官方微信